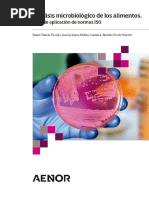

0 calificaciones0% encontró este documento útil (0 votos)
202 vistas0 páginasGuía Calidad Medios de Cultivo
Este documento presenta un proyecto de norma chilena sobre microbiología de alimentos para consumo humano y animal. Proporciona directrices generales para el aseguramiento de la calidad en la preparación de medios de cultivo en laboratorios. Establece términos y definiciones relacionados con medios de cultivo, control de calidad y aseguramiento de la calidad. También especifica requisitos mínimos y prácticas recomendadas para el control de calidad de medios de cultivo.
Cargado por
Josel GarciasurmayDerechos de autor
© Attribution Non-Commercial (BY-NC)
Nos tomamos en serio los derechos de los contenidos. Si sospechas que se trata de tu contenido, reclámalo aquí.
Formatos disponibles
Descarga como PDF, TXT o lee en línea desde Scribd
0 calificaciones0% encontró este documento útil (0 votos)
202 vistas0 páginasGuía Calidad Medios de Cultivo
Este documento presenta un proyecto de norma chilena sobre microbiología de alimentos para consumo humano y animal. Proporciona directrices generales para el aseguramiento de la calidad en la preparación de medios de cultivo en laboratorios. Establece términos y definiciones relacionados con medios de cultivo, control de calidad y aseguramiento de la calidad. También especifica requisitos mínimos y prácticas recomendadas para el control de calidad de medios de cultivo.
Cargado por
Josel GarciasurmayDerechos de autor
© Attribution Non-Commercial (BY-NC)
Nos tomamos en serio los derechos de los contenidos. Si sospechas que se trata de tu contenido, reclámalo aquí.
Formatos disponibles
Descarga como PDF, TXT o lee en línea desde Scribd
I
Vencimiento consulta pblica: 2008.06.27
PROYECTO DE NORMA EN CONSULTA PUBLICA
NCh3162.c2008
Microbiologa de los alimentos para consumo humano y
animal - Gua para la preparacin y produccin de medios
de cultivo - Parte 1: Directrices generales para el
aseguramiento de la calidad para la preparacin de
medios de cultivo en el laboratorio
Prembulo
El Instituto Nacional de Normalizacin, INN, es el organismo que tiene a su cargo el estudio y
preparacin de las normas tcnicas a nivel nacional. Es miembro de la INTERNATIONAL
ORGANIZATION FOR STANDARDIZATION (ISO) y de la COMISION PANAMERICANA DE
NORMAS TECNICAS (COPANT), representando a Chile ante esos organismos.
Este proyecto de norma se estudi a travs del Comit Tcnico Microbiologa de los
alimentos, para proporcionar la terminologa general relativa al aseguramiento de la calidad
para la preparacin de los medios de cultivo, y especificar los requisitos mnimos de
aplicacin en los anlisis microbiolgicos de productos destinados al consumo humano o
animal.
Este proyecto de norma es una traduccin modificada de la versin en ingls de la
Especificacin Tcnica Internacional ISO/TS 11133-1:2000 Microbiology of food and animal
feeding stuffs - Guidelines on preparation and production of culture media - Part 1: General
guidelines on quality assurance for the preparation of culture media in the laboratory.
Para los propsitos de este proyecto de norma, se han realizado los cambios editoriales
que se indican y justifican en Anexo E.
La Nota Explicativa incluida en un recuadro en clusula 2 Referencias normativas y en
Anexo Bibliografa, es un cambio editorial que se incluye con el propsito de informar la
correspondencia con norma chilena de la norma internacional citada en este proyecto de
norma.
NCh3162
II
En este proyecto de norma se han realizado modificaciones con respecto a la
especificacin tcnica internacional debido a la necesidad de armonizar este proyecto de
norma con otra norma chilena sobre el tema. Estas desviaciones tcnicas se han
incorporado al texto del proyecto de norma, y estn marcadas con una barra simple en los
mrgenes (I).
En Anexo E se incluye una lista completa de las desviaciones tcnicas, junto con su
justificacin.
Este proyecto de norma NCh3162 ha sido preparado por la Divisin de Normas del
Instituto Nacional de Normalizacin.
Los Anexos A, B, C, D y E no forman parte del proyecto de norma, se insertan slo a
ttulo informativo.
NCh3162
III
Contenido
Pgina
Prembulo I
0 Introduccin 1
1 Alcance y campo de aplicacin 2
2 Referencias normativas 2
3 Trminos y definiciones 3
3.1 Generalidades 3
3.2 Terminologa de aseguramiento de la calidad 3
3.3 Terminologa de los medios de cultivo 3
3.4 Terminologa de los organismos de control 6
4 Prcticas para el control de la calidad de los medios de cultivo 7
4.1 Documentacin 7
4.2 Almacenamiento 7
4.3 Preparacin de los medios en el laboratorio 9
4.4 Preparacin para el uso 12
4.5 Eliminacin de los medios 13
5 Control de la calidad de los productos finalizados 13
5.1 Control de la calidad fsico 13
5.2 Control de la calidad microbiolgica 14
NCh3162
IV
Contenido
Pgina
Anexos
Anexo A (informativo) Denominacin de los componentes de los medios de
cultivo en las normas de anlisis microbiolgico de los alimentos para consumo
humano y animal
16
A.1 Generalidades 16
A.2 Peptonas 16
A.3 Extractos 16
A.4 Agar 17
A.5 Otros 17
Anexo B (informativo) Gua para la conservacin y mantenimiento de cepas de
control
18
B.1 Generalidades 18
B.2 Cepas de referencia de origen comercial 18
B.3 Reserva de cepas de referencia preparadas en el laboratorio 18
B.4 Cultivos de trabajo 18
Anexo C (informativo) Aseguramiento de la calidad de los medios de cultivo -
Tabla de anomalas
20
Anexo D (informativo) Bibliografa 21
Anexo E (informativo) Justificacin de las desviaciones tcnicas y cambios
editoriales
22
NCh3162
V
Contenido
Pgina
Figuras
Figura B.1
19
Tablas
Tabla E.1 Desviaciones tcnicas
22
Tabla E.2 Cambios editoriales 22
1
Vencimiento consulta pblica: 2008.06.27
PROYECTO DE NORMA EN CONSULTA PUBLICA
NCh3162.c2008
Microbiologa de los alimentos para consumo humano y
animal - Gua para la preparacin y produccin de medios
de cultivo - Parte 1: Directrices generales para el
aseguramiento de la calidad para la preparacin de
medios de cultivo en el laboratorio
0 Introduccin
En el laboratorio de microbiologa muchos anlisis y procedimientos dependen de que el
medio de cultivo sea constante y proporcione resultados reproducibles. Los medios de
cultivo se emplean en todas las tcnicas de cultivo tradicionales y tambin en muchas
tcnicas alternativas. Numerosas frmulas de medios de cultivo deshidratados estn
disponibles comercialmente y muchas ms, destinadas a crecimientos especficos, se
encuentran descritas en la literatura. Adicionalmente, en los laboratorios que realizan
exmenes microbiolgicos de productos alimenticios, los principales objetivos son el
mantenimiento, revivificacin, crecimiento, deteccin y/o recuento de una amplia variedad
de microorganismos. Los requisitos que han de reunir los medios son especficos tanto
para la muestra como para los organismos que se van a detectar. Los medios de cultivo
han de cumplir unos criterios mnimos de rendimiento que constituyen por ello una
condicin previa a todo anlisis microbiolgico fiable. Conviene realizar un nmero de
anlisis suficiente para demostrar:
i) la aceptabilidad de cada lote de medio;
ii) que el medio es adecuado al objetivo; y
iii) que el medio puede dar resultados constantes.
Estos tres criterios son una parte esencial de los procedimientos de control interno de
calidad y, con la documentacin adecuada, permitirn una supervisin eficaz de los
medios de cultivo y contribuirn a la obtencin de los datos precisos y fiables.
NCh3162
2
1 Alcance y campo de aplicacin
Esta norma proporciona la terminologa general relativa al aseguramiento de la calidad para
la preparacin de los medios de cultivo, y especifica los requisitos mnimos de aplicacin
en los anlisis microbiolgicos de productos destinados al consumo humano o animal.
Estos requisitos son aplicables a tres categoras de medios de cultivo empleados en los
laboratorios que preparan y/o utilizan medios de cultivo para realizar sus anlisis
microbiolgicos:
- medios comerciales listos para su empleo;
- medios preparados a partir de frmulas deshidratadas comerciales (sean completos,
por ejemplo, agar para recuento en placa, o sean medios base a los que se les aaden
suplementos, por ejemplo agar de Baird-Parker);
- medios preparados a partir de sus componentes individuales.
2 Referencias normativas
Los documentos referenciados siguientes son indispensables para la aplicacin de esta
norma. Para referencias con fecha, slo se aplica la edicin citada. Para referencias sin
fecha se aplica la ltima edicin del documento referenciado (incluyendo cualquier
enmienda).
NCh9000.Of2001
ISO 9000:2000
Sistemas de gestin de la calidad - Fundamentos y vocabulario.
EN 1659:1996 In vitro diagnostic systems - Culture media for microbiology -
Terms and definitions.
EN 12322:1999 In vitro diagnostic medical devices - Culture media for microbiology
- Performance criteria for culture media.
NOTA EXPLICATIVA NACIONAL
La equivalencia de la norma internacional sealada anteriormente con norma chilena, y su grado de
correspondencia es el siguiente:
Norma internacional Norma nacional Grado de correspondencia
ISO 9000:2000 NCh9000.Of.2001 Idntica
NCh3162
3
3 Trminos y definiciones
Para los propsitos de esta norma, se aplican los trminos y definiciones siguientes:
3.1 Generalidades
Esta clusula establece las definiciones generales referentes al aseguramiento de la
calidad y proporciona diferentes tipos de terminologa relacionada con los medios de
cultivo y los cultivos de control. Las normas citadas entre corchetes indican que el texto
dado es idntico a la fuente citada.
3.2 Terminologa de aseguramiento de la calidad
3.2.1 aseguramiento de la calidad: parte de la gestin de la calidad orientada a
proporcionar confianza en que se cumplirn los requisitos de la calidad
[NCh-ISO 9000]
3.2.2 control de la calidad: parte de la gestin de la calidad orientada al cumplimiento de
los requisitos de la calidad
[NCh-ISO 9000]
3.2.3 control de calidad interno: programa de control continuo de las actividades de un
laboratorio preparado por o para l, y basado en los anlisis de control y de seguimiento y
sobre las acciones correctivas si fueran necesarias
3.2.4 lote de los medios de cultivo: unidad que permite una trazabilidad completa referida
a una cantidad definida de producto a granel, producto semiterminado o producto final,
que es coherente en tipo y calidad, y ha cumplido los requisitos de los ensayos de
produccin (control durante el proceso) y de garanta de la calidad, y que ha sido
producido durante un perodo de produccin definido al que se le ha asignado el mismo
nmero de lote
[EN 12322]
3.2.5 rendimiento del medio de cultivo: respuesta de un medio de cultivo sometido a
cepas de control bajo condiciones definidas
3.3 Terminologa de los medios de cultivo
3.3.1 medio de cultivo: formulacin de sustancias en forma lquida, semislida o slida,
que contienen constituyentes naturales y/o sintticos destinados a facilitar la
multiplicacin o a mantener la viabilidad de los microorganismos
NOTA - Cuando se utiliza formando parte de palabras compuetas, este trmino se abrevia a menudo con la
palabra medio (por ejemplo, medio de enriquecimiento).
[EN 1659]
NCh3162
4
3.3.2 Medios de cultivo clasificados segn su composicin
3.3.2.1 medio de cultivo de composicin qumica definida: medio de cultivo formado
nicamente por constituyentes qumicamente definidos (es decir, de estructura molecular
y el grado de pureza conocidos)
[EN 1659]
3.3.2.2 medio de cultivo de composicin qumica incompleta: medio de cultivo formado
total o parcialmente por materias primas naturales, procesado o de otra manera, cuya
composicin qumica no est definida de forma completa
NOTA - Para los diversos componentes no definidos qumicamente empleados en los medios de cultivo, el
ISO/TC 34/SC 9 ha establecido una lista armonizada de denominaciones, ver Anexo A.
3.3.3 Medios de cultivo clasificados por su consistencia
3.3.3.1 medio de cultivo quido: medio de cultivo que consiste en una solucin acuosa de
uno o ms constituyentes (por ejemplo, agua de peptona, caldo nutritivo)
NOTAS
1) En algunos casos se aaden partculas slidas al medio de cultivo lquido.
2) Los medios lquidos en tubos, matraces o frascos se denominan comnmente caldos.
[EN 1659]
3.3.3.2 medio de cultivo slido y medio de cultivo semislido: medio de cultivo lquido
que contiene materiales solidificantes (por ejemplo, agar-agar, gelatina, etc.) en diferentes
concentraciones
NOTAS
1) Debido a la utilizacin mundialmente extendida de los medios de cultivo solidificados con agar-agar, se
utiliza el trmino abreviado agar de forma sinnima para medios de cultivo slidos y por lo tanto formando
parte de otros trminos (por ejemplo, agar para recuento en placa).
2) Los medios de cultivo slidos vertidos en placas de Petri se llaman comnmente placas. Los medios de
cultivo slidos vertidos en tubos que se mantienen en posiciones inclinadas mientras se solidifican se
denominan a menudo agares inclinados.
[EN 1659]
3.3.4 Medios de cultivo clasificados por el uso al que se destinan
3.3.4.1 medio de transporte: medio de cultivo diseado para conservar y mantener la
viabilidad de los microorganismos durante el perodo de tiempo entre el momento del
muestreo y el procesamiento de la muestra en el laboratorio
NOTA - Los medios de transporte contienen normalmente sustancias que no permiten la multiplicacin de los
microorganismos pero que aseguran su conservacin (por ejemplo, medio de transporte de Stuart o de Amies).
[EN 1659]
NCh3162
5
3.3.4.2 medio de conservacin: medio de cultivo diseado para conservar y mantener la
viabilidad de los microorganismos durante un perodo de tiempo prolongado, para
protegerlos contra las influencias adversas que pueden ocurrir durante su almacenamiento
a largo plazo y para permitir su recuperacin despus de este perodo (por ejemplo, medio
de huevo de Dorset)
[EN 1659]
3.3.4.3 medio de revivificacin: medio de cultivo que permite a los microorganismos
lesionados y daados, reparar y recuperar su capacidad de crecimiento normal, sin
promover necesariamente su multiplicacin
[EN 1659]
3.3.4.4 medio de enriquecimiento: medio de cultivo generalmente lquido, que debido a su
composicin, proporciona unas condiciones particularmente favorables para la
multiplicacin de los microorganismos
[EN 1659]
3.3.4.4.1 medio de enriquecimiento selectivo: medio de enriquecimiento que favorece la
multiplicacin de microorganismos especficos mientras que inhibe parcial o totalmente el
crecimiento de otros microorganismos (por ejemplo, medio de Rappaport-Vassiliadis)
3.3.4.4.2 medio de enriquecimiento no selectivo: medio de enriquecimiento que favorece
el crecimiento de la mayora de los microorganismos (por ejemplo, caldo nutritivo)
3.3.4.5 medio de aislamiento: medio de cultivo slido o semislido que favorece el
crecimiento de microorganismos
3.3.4.5.1 medio de aislamiento selectivo: medio de aislamiento que favorece el
crecimiento de microorganismos especficos, a la vez que inhibe otros microorganismos
(por ejemplo, agar PALCAM, agar MacConkey)
[EN 1659]
3.3.4.5.2 medio de aislamiento no selectivo: medio de aislamiento que no est diseado
para la inhibicin selectiva de microorganismo (por ejemplo, agar nutritivo)
[EN 1659]
3.3.4.6 medio diferencial: medio de cultivo que permite el estudio de una o ms
caractersticas fisiolgicas/bioqumicas de los microorganismo para su identificacin
(por ejemplo, medio de urea, agar de Kligler)
NOTA - Los medios diferenciales que se pueden utilizar como medios de aislamiento se denominan medios de
aislamiento/diferencial [por ejemplo, agar xilosa lisina desoxicolato (XLD)].
[EN 1659]
NCh3162
6
3.3.4.7 medio de identificacin: medio de cultivo diseado para producir una reaccin de
identificacin especfica que no precisa ningn anlisis posterior de confirmacin
NOTA - Los medios de identificacin que se pueden emplear como medio de aislamiento se denominan medios
de aislamiento/identificacin.
[EN 1659]
3.3.4.8 medios para usos mltiples: ciertos medios de cultivo se pueden asignar a varias
categoras, por ejemplo, el agar-sangre es un medio de revivificacin segn 3.3.4.3, un
medio de aislamiento segn 3.3.4.5, y un medio diferencial segn 3.3.4.6, utilizado para
la deteccin de hemlisis
3.3.5 Medios de cultivo clasificados segn el mtodo de preparacin
3.3.5.1 medio listo para su empleo: medio de cultivo que se suministra en recipientes bajo
la forma de producto listo para su empleo (por ejemplo, placas de Petri, tubos u otros
recipientes)
3.3.5.2 medio de cultivo preparado a partir de frmulas comerciales deshidratadas: medio
de cultivo desecado que no est listo para su uso inmediato (por ejemplo, productos en
polvo, granulados o liofilizados). La rehidratacin producir uno de los dos tipos de medios
siguientes:
- un medio completo listo para su empleo;
- un medio incompleto al cual se aaden componentes lbiles justo antes de su uso.
3.3.5.3 Medio de cultivo preparado en el laboratorio a partir de sus componentes
individuales
3.4 Terminologa de los organismos de control
3.4.1 Generalidades
Se trata de microorganismos utilizados generalmente para el control de la calidad y de los
anlisis del rendimiento de los medios de cultivo. Se definen segn su origen de la forma
siguiente:
3.4.2 cepa de referencia: microorganismo definido al menos a nivel de gnero y especie,
catalogado y descrito segn sus caractersticas y preferiblemente indicando su origen
[EN 12322]
3.4.3 cepa de reserva de referencia: lote de cultivos obtenido en el laboratorio por una
sola propagacin a partir de una cepa de referencia, ya sea en el laboratorio o desde un
proveedor
[EN 12322]
3.4.4 cultivo de trabajo: subcultivo primario de una cepa de reserva de referencia
(ver 3.4.3)
NCh3162
7
4 Prcticas para el control de la calidad de los medios de cultivo
4.1 Documentacin
4.1.1 Documentacin requerida desde el fabricante
El fabricante debera suministrar la informacin siguiente:
- nombre del medio, constituyentes individuales y cualquier suplementos, y sus cdigos
de productos;
- nmero de lote;
- pH del medio antes de su uso;
- condiciones de almacenamiento y fecha de caducidad;
- cualquier evaluacin de su rendimiento y organismo de control utilizado;
- ficha tcnica;
- certificado de control de la calidad;
- ficha de datos de seguridad y/o peligrosidad, cuando sea necesaria.
4.1.2 Verificacin realizada por el laboratorio
Cuando se recibe el medio, el laboratorio comprueba los datos siguientes:
- nombre del medio y nmero de lote;
- fecha de recepcin;
- fecha de caducidad;
- condiciones e integridad del embalaje.
4.2 Almacenamiento
4.2.1 Generalidades
En todos los casos se seguirn las instrucciones del fabricante, cuando existan, en lo
referente a condiciones de almacenamiento, fecha de caducidad y uso.
NCh3162
8
4.2.2 Gestin y control de la calidad de medios deshidratados y suplementos
Los medios se adquieren generalmente de fabricantes comerciales. Se suministran en
forma de polvo deshidratado o en grnulos en recipientes sellados, y los suplementos de
las diferentes sustancias selectivas o de diagnstico se suministran bajo forma liofilizada o
lquida. Sin embargo, es conveniente planificar la recepcin para asegurar una rotacin
regular de los productos almacenados (es decir, primero que entra primero que sale). Para
mantener un inventario eficaz se deberan efectuar verificaciones suplementarias que
comprenden:
- una nueva verificacin del sellado;
- fecha de la primera vez que se abre;
- evaluacin visual del contenido de los recipientes abiertos.
La calidad del medio puede depender del ambiente del almacenamiento, especialmente
despus de abrir un nuevo recipiente. La prdida de la calidad de los medios deshidratados
se manifiesta por un cambio en las caractersticas de flujo del polvo, homogeneidad,
apelmazamiento, cambios de color, etc. Se debera desechar todo medio deshidratado que
haya absorbido humedad o muestre signos manifiestos de cambio en la apariencia fsica.
4.2.3 Medios comerciales listos para su empleo
Seguir las instrucciones del fabricante en lo referente a las condiciones de almacenamiento,
fecha de caducidad y uso.
4.2.4 Medios preparados a partir de frmulas deshidratadas disponibles comercialmente y
a partir de componentes individuales bsicos
El tiempo de conservacin de estos tipos de medios es variable. Por ello es difcil
establecer lmites de tiempo generales para el almacenamiento de los medios preparados.
Las normas internacionales o nacionales especficas pueden estipular las condiciones
especficas y el tiempo de conservacin.
Los medios de cultivo esterilizados dispensados en placas, tubos o frascos y los reactivos
que no vayan a ser utilizados inmediatamente deben ser protegidos de la luz y de la
desecacin.
A menos que se haya establecido una fecha de caducidad validada o est especificado en
la norma en cuestin, los medios parcialmente completos estriles, es decir los medios a
los cuales los componentes finales se aaden inmediatamente antes de su uso, se deben
mantener en refrigerador como mximo tres meses y un mes como mximo a temperatura
ambiente, en condiciones que eviten toda modificacin de su composicin. Sin embargo,
se recomienda que los medios a los que se les ha aadido suplementos selectivos lbiles
sean usados en el mismo da de su preparacin. No es conveniente que los medios slidos
que contengan reactivos qumicos y/o sustancias lbiles se almacenen en masa para
refundirlos posteriormente.
NCh3162
9
Hay que observar cualquier cambio de color, signo de evaporacin/deshidratacin o
crecimiento microbiano. Los lotes de medios que presenten tales cambios, no deberan ser
usados.
Se recomienda que antes de usar o antes de un calentamiento adicional, la temperatura de
los medios de cultivo se equilibre con la temperatura ambiente.
4.3 Preparacin de los medios en el laboratorio
4.3.1 Generalidades
La preparacin precisa de los medios de cultivo es una de las etapas fundamentales en el
examen microbiolgico y se le debe dedicar un cuidado especial.
Se han de respetar las buenas prcticas de laboratorio y las instrucciones del fabricante
respecto a la manipulacin de los medios deshidratados y otros componentes,
particularmente aquellos que contengan materiales peligrosos, es decir sales biliares u
otros agentes selectivos.
Cuando los medios se preparan a partir de frmulas deshidratadas comerciales, se
seguirn fielmente las instrucciones del fabricante. Hay que documentar todos los datos
importantes, es decir peso/volumen, pH, fecha de preparacin, condiciones de
esterilizacin, tcnico.
Para los medios preparados a partir de componentes individuales, se seguir fielmente la
receta y se registrarn todos los detalles (ver 4.1.2), as como la identificacin completa
(es decir cdigo y nmero de lote) de todos los constituyentes utilizados.
4.3.2 Agua
El agua utilizada debe ser destilada o agua de calidad equivalente, es decir libre de
sustancias que puedan inhibir o influir en el crecimiento de los microorganismos en las
condiciones de anlisis. Si el agua destilada se prepara a partir de agua clorada, neutralizar
el cloro antes de la destilacin.
El agua destilada debe ser almacenada en recipientes fabricados preferiblemente de
materiales inertes (por ejemplo, vidrio neutro, polietileno, etc.) que deben estar libres de
toda sustancia inhibidora antes de ser usados por primera vez.
NOTA - En algunos casos puede ser necesario usar agua recin preparada, libre de dixido de carbono disuelto.
Para que el agua destilada se pueda considerar de buena calidad, debe tener una
resistividad de al menos 300 000 cm.
ADVERTENCIA: El agua procesada a travs de un intercambiador de iones (desionizada) puede tener un alto
contenido en microorganismos; es por ello recomendable no utilizar este tipo de agua sin haber verificado
antes que el contenido de microorganismos en el agua es bajo. Es conveniente consultar al fabricante sobre la
mejor manera de minimizar la contaminacin microbiana. El agua desionizada muy contaminada que haya sido
esterilizada por filtracin, puede todava contener sustancias inhibidoras para el crecimiento de algunos
microorganismos.
NCh3162
10
4.3.3 Pesada y rehidratacin
Se pesa cuidadosamente la cantidad apropiada de medio deshidratado (teniendo cuidado
de no inhalar polvo, especialmente con medios que contengan sustancias txicas) y se
aade progresivamente la cantidad necesaria de agua evitando que se formen grumos.
4.3.4 Disolucin y dispersin
Los medios deshidratados necesitan para su disolucin una dispersin rpida mediante
una agitacin inmediata y repetida, seguida por calentamiento si es necesario. Para la
disolucin de los medios que contengan agar, es conveniente dejarlos a remojo durante
varios minutos antes de calentarlos con agitacin para disolverlos. Para los medios
preparados a partir de sus componentes individuales, cada componente se debera aadir
separadamente y dejarlo disolver antes de completar el volumen final.
4.3.5 Medida y ajuste de pH
Se mide el pH utilizando un pHmetro y se ajusta si es necesario, es decir para los medios
preparados a partir de sus componentes individuales en el laboratorio se ajusta de tal
forma que despus de la esterilizacin y enfriamiento a 25C el medio est al pH
requerido 0,2 unidades de pH, salvo que se indique otra cosa. El ajuste se realiza
normalmente empleando una disolucin de hidrxido sdico (NaOH) de aproximadamente
40 g/L (alrededor de 1 mol/L) o de cido clorhdrico (HCl) de aproximadamente 36,5 g/L
(alrededor de 1 mol/L).
NOTA - Los medios de cultivo comerciales pueden mostrar cambios significativos de pH antes y despus de
ser sometidos al autoclave. Sin embargo, siempre que se use agua destilada o desionizada de buena calidad, el
ajuste del pH antes de introducir en el autoclave no debera ser necesario.
4.3.6 Dispensacin
Se dispensa el medio en recipientes adecuados que tengan un volumen de 1, 2 a 3 veces
el del medio.
4.3.7 Esterilizacin
4.3.7.1 Generalidades
La esterilizacin de los medios de cultivo y de los reactivos se puede realizar empleando
esterilizacin mediante calor hmedo (ver 4.3.7.2) o esterilizacin mediante filtracin
(ver 4.3.7.3).
Ciertos medios no necesitan esterilizacin por autoclave sino que se pueden utilizar
despus de haber sido llevados a ebullicin. Por ejemplo, medios para Enterobacteriaceae
que contienen verde brillante son particularmente sensibles al calor y a la luz y deberan
ser enfriados rpidamente despus de la ebullicin y protegidos de la luz intensa.
Igualmente algunos reactivos se pueden usar sin esterilizacin (referirse a la norma
apropiada o a las instrucciones del fabricante).
NCh3162
11
4.3.7.2 Esterilizacin mediante calor hmedo
La esterilizacin mediante calor hmedo se realiza en autoclave o en un aparato
preparador de medios. Generalmente la esterilizacin por autoclave se efecta
durante 15 min a 121C. Para volmenes mayores que 1 000 ml, es necesario adaptar el
ciclo de esterilizacin. En todos los casos, se seguirn las instrucciones dadas en las
normas o las instrucciones de los fabricantes. Es conveniente controlar el funcionamiento
del autoclave mediante perfiles de temperatura empleando termopares y papel reactivo
bajo condiciones de cargas tpicas para asegurar que las temperaturas deseadas se
puedan alcanzar.
NOTA - Se puede producir un sobrecalentamiento cuando se someten al autoclave grandes cantidades de
medio (> 1 000 ml).
El control de la eficacia de la esterilizacin es esencial.
Despus del calentamiento del medio, es esencial enfriarlo de manera que se evite que se
desborde. Esto es particularmente importante en los medios sensibles como por ejemplo, para
las Enterobacteriaceae y para los medios en grandes volmenes.
4.3.7.3 Esterilizacin por filtracin
La esterilizacin por filtracin se puede realizar por vaco o por presin. Se usan
membranas o filtros con un dimetro de poro de 0,22 m. Deben haber sido esterilizados
en el autoclave. Para el empleo de filtros o membranas que se hayan adquirido estriles,
referirse a las instrucciones del fabricante. Los diferentes elementos de los aparatos de
filtracin, montados o no, deben ser esterilizados en el autoclave durante 15 min
a 121C. Si es necesario, el montaje asptico se puede realizar en una cmara de flujo
laminar despus de ser sometidos al autoclave.
NOTA - Algunos filtros de membrana pueden retener protenas (como los antibiticos). A fin de obtener la
concentracin adecuada, el usuario debera humedecer previamente el filtro.
4.3.7.4 Monitoreo
Despus de la esterilizacin por autoclave, ebullicin o filtracin, todos los medios se
deberan monitorear, en particular en lo referente al pH, color, esterilidad y consistencia.
4.3.8 Preparacin de los suplementos
Los suplementos comerciales que contengan agentes txicos, particularmente antibiticos,
deben ser manipulados con cuidado, evitando la dispersin del polvo que podra dar lugar a
alergias o a otras reacciones en el personal del laboratorio. Se tomarn las precauciones
necesarias y se seguirn las instrucciones del fabricante durante la preparacin de las
disoluciones. No se sobrepasar la fecha lmite de conservacin, que es generalmente el
mismo da para las disoluciones de trabajo de antibiticos. Bajo ciertas circunstancias, las
disoluciones de antibiticos pueden ser almacenadas congeladas en alcuotas apropiadas,
pero no se deberan volver a congelar despus de ser descongeladas. La prdida potencial
de actividad debido a la congelacin se debera discutir con el fabricante o ser determinada
por el usuario.
NCh3162
12
4.4 Preparacin para el uso
4.4.1 Fusin de los medios de cultivo con agar
Se funde un medio de cultivo situndolo en un bao de agua hirviendo o por cualquier
otro procedimiento que d resultados idnticos (por ejemplo, en autoclave a vapor
fluente). Los medios que han sido previamente esterilizados en autoclave deberan ser
recalentados durante un tiempo mnimo para mantener la calidad de los medios. Hay que
evitar un calentamiento excesivo y retirarlo cuando est fundido. Se enfra el medio
fundido a 47C 2C en un bao de agua controlado termostticamente hasta el
momento de su empleo. El tiempo necesario para alcanzar los 47C depende del tipo de
medio, del volumen y del nmero de recipientes que haya en el bao de agua. Los medios
de cultivo refundidos se deberan usar lo ms pronto posible, y se recomienda no
conservarlos ms de 4 h.
4.4.2 Desgasificacin de los medios de cultivo
Si es necesario, justo antes de su uso, calentar el medio de cultivo en agua hirviendo o
bajo vapor fluente durante 15 min, con tapones flojos; despus del calentamiento, se
aprietan los tapones y se enfra rpidamente hasta la temperatura de utilizacin.
4.4.3 Adicin de suplementos
Los suplementos termolbiles se deberan aadir al medio despus de que ste haya sido
enfriado a 47C 2C. Los suplementos estriles se deben estabilizar a temperatura
ambiente antes de aadirlos al medio de agar. Los lquidos fros pueden hacer que el agar
se solidifique o que se formen copos transparentes. Se mezclan con precaucin y
completamente todos los suplementos con el medio y despus se transfiere a los
recipientes finales lo ms rpidamente posible.
4.4.4 Preparacin y almacenamiento de los medios en placas de Petri
Se vierte el medio de cultivo de agar fundido en placas de Petri de manera que se obtenga
un espesor de al menos 2 mm (por ejemplo, para placas de 90 mm de dimetro, se
necesitan normalmente 15 ml de agar). Se deja el agar solidificar y enfriar situando las
placas de Petri, con las tapas en su lugar, en una superficie fresca y horizontal.
NOTA - Durante la incubacin se produce una prdida de humedad del medio de agar. Una prdida mayor
que 15% del contenido en agua puede en algunas circunstancias afectar adversamente al crecimiento de
microorganismos. Los factores que influyen en la prdida de agua son la composicin del medio, la cantidad de
medio en las placas, el tipo de estufa de incubacin (es decir, con ventilacin o de otro tipo), humedad de la
atmsfera en la estufa de incubacin, la posicin y el nmero de placas en la estufa de incubacin y la
temperatura de incubacin.
NCh3162
13
El medio solidificado se emplea inmediatamente o se conserva en condiciones que eviten
toda modificacin de su composicin, es decir en oscuridad y/o en refrigerador entre 4C
y 12C en bolsas selladas, durante un tiempo mximo de una semana o lo indicado por el
fabricante o la norma especfica. Se etiquetan las placas en la base con la fecha de
preparacin y/o la fecha de caducidad y la identificacin del medio. Alternativamente se
pueden utilizar sistemas de cdigos que renan estos requisitos.
El tiempo de conservacin de las placas se incrementar si se almacenan en bolsas de
plstico selladas. Para evitar que se produzca condensacin, las placas se debern enfriar
antes de introducirse en las bolsas. No se deben secar las superficies de las placas de
agar antes de almacenarlas en el refrigerador.
En general, para la siembra en superficie de un medio de cultivo slido, se secan las
placas, preferiblemente con las tapas retiradas y con la superficie del agar mirando hacia
abajo, en una estufa regulada entre 25C y 50C o en una cabina de flujo laminar, hasta la
desaparicin de las gotas de la superficie del medio. No se deben secar demasiado. Las
placas comerciales listas para su empleo se deberan almacenar y utilizar segn las
instrucciones del fabricante.
4.4.5 Incubacin
Apilar las placas en nmero no mayor a seis unidades y dejar espacio para que circule el
aire, de tal forma que el medio de cultivo se equilibre con la temperatura de incubacin lo
ms rpidamente posible. En el caso de medios lquidos, el tiempo para alcanzar la
temperatura de incubacin depende de varios factores, por ejemplo, el volumen, la carga,
el recipiente, el tipo de estufa. Si se utilizan jarras de anaerobios puede ser necesario
apilar ms de seis placas.
4.5 Eliminacin de los medios
Tanto los medios contaminados como los no utilizados deben ser eliminados de una
manera que sea segura y que cumpla las reglamentaciones locales o nacionales.
5 Control de la calidad de los productos finalizados
5.1 Control de la calidad fsico
Los controles de laboratorio deberan incluir como mnimo:
- valor del pH medido entre 20C y 25C;
y mediante observacin:
- cantidad repartida y/o espesor de la capa;
- color;
NCh3162
14
- claridad/presencia de defectos pticos;
- estabilidad del gel/consistencia/humedad.
5.2 Control de la calidad microbiolgica
5.2.1 Contaminacin
Una cantidad apropiada de cada lote debera ser analizada para verificar la ausencia de
contaminacin.
5.2.2 Cepas de control
Un lote de cepas de control debera contener slo microorganismos con caractersticas
estables, que sean representativos de sus especies y que se hayan mostrado fiables para
la comprobacin del comportamiento ptimo de un medio en particular preparado en el
laboratorio. Las cepas de control deberan incluir principalmente cepas que estn
disponibles fcilmente en colecciones de cultivos de referencia, pero tambin se pueden
incluir cepas bien caracterizadas aisladas en el laboratorio. Se deberan examinar y
registrar en el laboratorio las caractersticas principales de los cultivos de reserva y
renovar las cepas si aparecen caractersticas atpicas. Se utilizarn preferentemente cepas
de origen alimentario, aunque no todas las colecciones de cultivo suministran este tipo de
informacin sobre su origen.
Las cepas de control para cada medio pueden incluir:
- cepas robustas positivas que muestren caractersticas tpicas;
- cepas positivas que crecen dbilmente (es decir de una naturaleza ms sensible);
- cepas bioqumicamente no reactivas, por ejemplo, aquellas que muestren reacciones
diferentes de fermentacin o de fluorescencia;
- cepas completamente inhibidas.
NOTA - El grupo de trabajo sobre medios de cultivo (WPCM) del International Committee for Food Microbiolgoy
and Hygiene ha recomendado una coleccin validada de cepas de control para la evaluacin de los medios
(ver Anexo D, [1]).
5.2.3 Medios y reactivos listos para su uso
Los fabricantes de medios comerciales listos para su uso, particularmente si estn
certificados segn ISO 9001 (ver Anexo D, [2]), tendrn un programa de calidad en
funcionamiento y pueden acompaar los medios que suministren con un certificado de
calidad. Bajo estas condiciones el usuario puede no necesitar realizar pruebas extensas de
dichos medios, pero se debera asegurar que las condiciones de conservacin establecidas
se mantengan.
NCh3162
15
5.2.4 Medios preparados a partir de formulaciones deshidratadas disponibles comercialmente
Para los propsitos de esta norma, las exigencias mnimas son unas pruebas cualitativas
para cada lote del medio preparado, pero cuando se van a realizar exmenes cuantitativos
de muestras, las pruebas cuantitativas de cada lote darn una mayor seguridad de la
calidad de los medios. Para aquellos medios que no contienen indicadores o agentes
selectivos, es suficiente el uso de una sola cepa de control positiva. Para aquellos medios
que contienen indicadores o agentes selectivos, se deben utilizar cepas que demuestren la
funcin del (de los) indicador(es) y la selectividad. Para los medios complejos, es decir con
suplementos adicionados, cada lote se debera verificar con cepas con las caractersticas
indicadas en 5.2.2. Lo mismo se aplica al caso de los medios listos para su uso a los
cuales se han adicionado suplementos preparados en el laboratorio.
5.2.5 Medios preparados a partir de componentes bsicos individuales
Se recomienda que adems de las pruebas cualitativas descritas en 5.2.4 se realicen
algunas pruebas cuantitativas utilizando tcnicas como la de Miles & Misra modificada
(ver Anexo D, [1]) o siembra en espiral, para evaluar as la calidad de los componentes de
base, la productividad del medio y los procedimientos internos de elaboracin en el
laboratorio.
NOTA - Estas son directrices mnimas, pero en la prctica los alimentos pueden contener microorganismos
lesionados. Se debera tener en cuenta la capacidad del medio respecto a la recuperacin de las clulas
lesionadas. Para informacin sobre las tcnicas de conservacin, mantenimiento y sobre las colecciones de
cultivos de referencia, ver Anexo B.
NCh3162
16
Anexo A
(Informativo)
Denominacin de los componentes de los medios de cultivo en las normas
de anlisis microbiolgico de los alimentos para consumo humano y animal
A.1 Generalidades
Con el fin de armonizar la descripcin de los diferentes componentes en la composicin de
los medios de cultivo en los mtodos microbiolgicos normalizados, el ISO/TC 34/SC 9
Productos agrcolas y alimenticios - Microbiologa decidi las denominaciones para las
categoras de los componentes designados en clusulas A.2 a A.5.
A.2 Peptonas
- digerido enzimtico de casena
1)
;
- digerido enzimtico de harina de soja;
- digerido enzimtico de tejidos animales
2)
;
- digerido enzimtico de corazn;
- digerido enzimtico de gelatina;
- digerido enzimtico de tejidos de animales y plantas.
A.3 Extractos
- extracto de carne;
- extracto de cerebro-corazn;
- extracto de levadura;
- bilis de buey para uso bacteriolgico;
- sales biliares;
- sales biliares N 3.
1) Incluye digerido pptico de casena, digerido trptico de casena y triptona.
2) Incluye peptona de carne, digerido pptico de carne, digerido pancretico de carne.
NCh3162
17
A.4 Agar
- agar bacteriolgico.
A.5 Otros
- emulsin de yema de huevo;
- leche descremada en polvo;
- hidrolizado cido de casena.
NCh3162
18
Anexo B
(Informativo)
Gua para la conservacin y mantenimiento de cepas de control
B.1 Generalidades
Para la conservacin y el mantenimiento eficaz de todos los microorganismos de inters
en microbiologa de los alimentos hay varios mtodos disponibles, como la liofilizacin,
conservacin en bolitas a -70C o empleando nitrgeno lquido. Un mtodo puede no ser
apropiado para todas las cepas.
Estas directrices de conservacin se presentan en Figura B.1.
B.2 Cepas de referencia de origen comercial
Si las cepas de referencia procedentes de colecciones de referencia o de proveedores
comerciales aprobados segn ISO 9001 (ver Anexo D, [2]), se adquieren y mantienen en
sus recipientes originales, se deben seguir las instrucciones de los fabricantes para su
cultivo y utilizacin.
B.3 Reserva de cepas de referencia preparadas en el laboratorio
Los cultivos de reserva de cepas de referencia (ver clusula B.2) para el control de calidad
y para ensayos de rendimiento, se deben mantener y manipular de manera que se reduzca
al mnimo la posibilidad de contaminacin cruzada, mutacin o alteracin de las
caractersticas tpicas. Las reservas de cepas de referencia se deberan almacenar en
mltiples alcuotas ya sea ultracongeladas (-70C) o liofilizadas. Se debera documentar
exhaustivamente las caractersticas de crecimiento para cada uno de los medios sobre/en
los que sern utilizadas como cepas de control.
B.4 Cultivos de trabajo
Los cultivos de trabajo se preparan a partir de las reservas de cepas de referencia
liofilizadas o ultracongeladas (ver clusula B.3). Las alcuotas deben ser manejadas de tal
manera que se evite la posible contaminacin cruzada de la cepa de reserva de referencia
y/o su deterioro. Los cultivos de trabajo se deberan preparar resuspendiendo una alcuota
de la cepa de reserva de referencia en un medio de crecimiento no selectivo e incubndolo
hasta obtener una fase de cultivo estacionaria.
En el caso de sistemas de conservacin comerciales, las instrucciones del fabricante se
deben seguir rigurosamente.
NCh3162
19
NOTA - No se deberan realizar subcultivos a partir de cultivos de trabajo. Sin embargo, los cultivos de trabajo
se puede utilizar ms de una vez, siempre que sean manipulados y conservados adecuadamente, es decir
evitando las contaminaciones cruzadas y/o su deterioro, y nunca durante ms de una semana.
Cepa de referencia
Obtenida de una coleccin de cultivos de
referencia, liofilizada y al vaco; o un organismo
definido al menos al nivel de gnero y especie,
altamente caracterizado y de origen conocido
Cepa de reserva
de referencia
Una serie de alcuotas de cultivos idnticos
obtenidos en el laboratorio de un subcultivo
nico de la cepa de referencia
Cultivo de trabajo
Un subcultivo primario a partir de una alcuota
de la cepa de reserva de referencia
Figura B.1
NCh3162
20
Anexo C
(Informativo)
Aseguramiento de la calidad de los medios de cultivo - Tabla de anomalas
Anomalas Razones posibles
No se solidifica el medio de agar Sobrecalentamiento del medio durante su preparacin
pH bajo que produce una hidrlisis cida
Pesada incorrecta del agar utilizado
Agar no disuelto totalmente
Mala mezcla de los ingredientes
pH incorrecto Sobrecalentamiento del medio durante su preparacin
Mala calidad del agua
Contaminacin qumica externa
Medicin del pH a temperatura inadecuada
Calibracin incorrecta del pHmetro
Mala calidad del medio deshidratado
Color anormal Sobrecalentamiento del medio durante su preparacin
Mala calidad del agua
Mala calidad del medio deshidratado
pH incorrecto
Contaminacin externa
Formacin de precipitados Sobrecalentamiento del medio durante su preparacin
Mala calidad del agua
Mala calidad del medio deshidratado
Control del pH inadecuado
Medio inhibidor/baja productividad Sobrecalentamiento del medio durante su preparacin
Mala calidad del medio deshidratado
Mala calidad del agua
Uso de una formulacin incorrecta, por ejemplo, ingredientes
que no se han pesado correctamente, suplementos adicionados
a concentracin errnea
Dbil selectividad Sobrecalentamiento del medio durante su preparacin
Mala calidad del medio deshidratado
Uso de una formulacin incorrecta
Suplementos mal adicionados, por ejemplo, cuando el medio
est demasiado caliente o adicionados a concentracin errnea
NCh3162
21
Anexo D
(Informativo)
Bibliografa
[1] Culture media for Food Microbiology - Progress in Industrial Microbiology, Vol. 34
(1995). Eds. Corry J.E.L., Curtis, G.D.W. and Baird, R.M. Elsevier, Amsterdam.
[2] NCh9001.Of2001
ISO 9001:2000
Sistemas de gestin de la calidad - Requisitos.
NOTA EXPLICATIVA NACIONAL
La equivalencia de la norma internacional sealada anteriormente con norma chilena, y su grado de
correspondencia es el siguiente:
Norma internacional Norma nacional Grado de correspondencia
ISO 9001:2000 NCh9001.Of.2001 Idntica
NCh3162
22
Anexo E
(Informativo)
Justificacin de las desviaciones tcnicas y cambios editoriales
Tabla E.1 Desviaciones tcnicas
Clusula/Subclusula Desviaciones tcnicas Justificacin
3.2.1 Se reemplaza la definicin por la contenida en
NCh9000.Of2001 - ISO 9000:2000
Actualizar definicin
3.2.2 Se reemplaza la definicin por la contenida en
NCh9000.Of2001 - ISO 9000:2000
Actualizar definicin
5.2.3; B.2; Anexo D Se elimina la referencia a ISO 9002 Norma anulada
Tabla E.2 Cambios editoriales
Clusula/Subclusula Cambios editoriales Justificacin
5.2.4 Se reemplaza esta parte de la norma
ENV ISO/TR 11133-1 por esta norma
La norma es de alcance
nacional
También podría gustarte
- Reglamento Técnico Centroamericano de Etiquetado Nutricional de Productos Alimenticios Preenvasados PDFAún no hay calificacionesReglamento Técnico Centroamericano de Etiquetado Nutricional de Productos Alimenticios Preenvasados PDF36 páginas
- Criterios Microbiológicos en AlimentosAún no hay calificacionesCriterios Microbiológicos en Alimentos35 páginas
- Crecimiento Microbiano: Claves y ProcesosAún no hay calificacionesCrecimiento Microbiano: Claves y Procesos97 páginas
- Validación de Métodos Analíticos en QAAún no hay calificacionesValidación de Métodos Analíticos en QA37 páginas
- Esterilidad Comercial en Alimentos NTC 5750Aún no hay calificacionesEsterilidad Comercial en Alimentos NTC 575030 páginas
- Guía de Microbiología de AlimentosAún no hay calificacionesGuía de Microbiología de Alimentos43 páginas
- Contaminación Microbiana en Azúcar y MielAún no hay calificacionesContaminación Microbiana en Azúcar y Miel12 páginas
- Criterios Microbiológicos FarmacéuticosAún no hay calificacionesCriterios Microbiológicos Farmacéuticos4 páginas
- Protocolo de Aislamiento de Salmonella spp.Aún no hay calificacionesProtocolo de Aislamiento de Salmonella spp.34 páginas
- Muestreo de Alimentos según Normas INENAún no hay calificacionesMuestreo de Alimentos según Normas INEN8 páginas
- Curso de Manipulación y Higiene AlimentariaAún no hay calificacionesCurso de Manipulación y Higiene Alimentaria28 páginas
- Medios de Cultivo y Uso en MicrobiologíaAún no hay calificacionesMedios de Cultivo y Uso en Microbiología30 páginas
- Métodos de Laboratorio - BAM - Métodos Microbiológicos para CosméticosAún no hay calificacionesMétodos de Laboratorio - BAM - Métodos Microbiológicos para Cosméticos12 páginas
- USP-51 - Pruebas de Eficacia AntimicrobianaAún no hay calificacionesUSP-51 - Pruebas de Eficacia Antimicrobiana4 páginas
- Pruebas de Esterilidad y Medios de CultivoAún no hay calificacionesPruebas de Esterilidad y Medios de Cultivo10 páginas
- Beneficios del CBD y Terapias AvanzadasAún no hay calificacionesBeneficios del CBD y Terapias Avanzadas10 páginas
- Aseguramiento de Calidad y Validación de MetodologíaAún no hay calificacionesAseguramiento de Calidad y Validación de Metodología85 páginas
- Version For PDF Millipore-WEBINAR ISO 16140-3 LATAMAún no hay calificacionesVersion For PDF Millipore-WEBINAR ISO 16140-3 LATAM58 páginas
- Norma ISO para Materiales de ReferenciaAún no hay calificacionesNorma ISO para Materiales de Referencia3 páginas
- Cosméticos-Microbiología - Instrucciones Generales para El Examen Microbiológico100% (1)Cosméticos-Microbiología - Instrucciones Generales para El Examen Microbiológico5 páginas
- Evaluación de Métodos Microbiológicos en AlimentosAún no hay calificacionesEvaluación de Métodos Microbiológicos en Alimentos18 páginas
- Listeria monocytogenes: Guía para el Sector AlimentarioAún no hay calificacionesListeria monocytogenes: Guía para el Sector Alimentario271 páginas
- Norma Mexicana de Buenas Prácticas de FármacosAún no hay calificacionesNorma Mexicana de Buenas Prácticas de Fármacos49 páginas
- Eficacia de Inhibidores de Moho en Piensos100% (1)Eficacia de Inhibidores de Moho en Piensos22 páginas
- S1 - Manejo e Interpretación de Farmacopea para Ensayos Microbiológicos (VL)Aún no hay calificacionesS1 - Manejo e Interpretación de Farmacopea para Ensayos Microbiológicos (VL)54 páginas
- Guia Interpretacion Enterobacterias PDFAún no hay calificacionesGuia Interpretacion Enterobacterias PDF6 páginas
- Manual Vibrio Cholerae Aislamientoy CaracterizaciónAún no hay calificacionesManual Vibrio Cholerae Aislamientoy Caracterización47 páginas
- 5 de 9 - Validacion de Metodos Microbiologicos100% (1)5 de 9 - Validacion de Metodos Microbiologicos20 páginas
- Análisis Microbiológico de Superficies AlimentariasAún no hay calificacionesAnálisis Microbiológico de Superficies Alimentarias13 páginas
- Verificación Intralaboratorio de La Norma Iso 6579: Método Horizontal para La Detección de Salmonella Spp. en Fórmula en Polvo para LactantesAún no hay calificacionesVerificación Intralaboratorio de La Norma Iso 6579: Método Horizontal para La Detección de Salmonella Spp. en Fórmula en Polvo para Lactantes4 páginas
- Ciclo de Vida y Validación en Productos FarmacéuticosAún no hay calificacionesCiclo de Vida y Validación en Productos Farmacéuticos15 páginas
- Prueba Esterilidad Comercial INVIMAAún no hay calificacionesPrueba Esterilidad Comercial INVIMA4 páginas
- Análisis Microbiológico de Empaque MBM055918Aún no hay calificacionesAnálisis Microbiológico de Empaque MBM0559182 páginas
- Monitoreo Microbiologico de Ambientes 2020100% (2)Monitoreo Microbiologico de Ambientes 202056 páginas
- Gtc78 Prepracion de Medios de CultivoAún no hay calificacionesGtc78 Prepracion de Medios de Cultivo23 páginas
- Guía de Calidad en Medios de CultivoAún no hay calificacionesGuía de Calidad en Medios de Cultivo8 páginas
- NTC4092 Analisis de Alimentos AnimalesAún no hay calificacionesNTC4092 Analisis de Alimentos Animales52 páginas
- Normas Microbiológicas en Productos de PescaAún no hay calificacionesNormas Microbiológicas en Productos de Pesca32 páginas
- Introducción a la Química de SuperficiesAún no hay calificacionesIntroducción a la Química de Superficies3 páginas
- Cotización Viaje Barranquilla-La HabanaAún no hay calificacionesCotización Viaje Barranquilla-La Habana2 páginas
- Guía ASEFAPI: Laboratorios de PinturasAún no hay calificacionesGuía ASEFAPI: Laboratorios de Pinturas91 páginas
- Test Elecsys HCG para Diagnóstico EmbarazoAún no hay calificacionesTest Elecsys HCG para Diagnóstico Embarazo4 páginas
- Práctica de Mecánica de Suelos en MineríaAún no hay calificacionesPráctica de Mecánica de Suelos en Minería7 páginas
- Normas de Seguridad en LaboratorioAún no hay calificacionesNormas de Seguridad en Laboratorio7 páginas
- Conservacion de Muestras BiologicasAún no hay calificacionesConservacion de Muestras Biologicas58 páginas
- Importancia de Exámenes Complementarios en VeterinariaAún no hay calificacionesImportancia de Exámenes Complementarios en Veterinaria4 páginas
- Guía de Visitas de Seguimiento en Ensayos ClínicosAún no hay calificacionesGuía de Visitas de Seguimiento en Ensayos Clínicos9 páginas
- Presentación Laboratorio Kasem - Anphoterol®Aún no hay calificacionesPresentación Laboratorio Kasem - Anphoterol®16 páginas
- Protocolos de Desinfección en SaludAún no hay calificacionesProtocolos de Desinfección en Salud2 páginas
- Procedimiento de Rechazo de MuestrasAún no hay calificacionesProcedimiento de Rechazo de Muestras2 páginas
- Optimización de Crudo Pesado con Mejoradores100% (1)Optimización de Crudo Pesado con Mejoradores8 páginas
- Manual - Estudiantes - Química Orgánica II Rev 2024 - 2025Aún no hay calificacionesManual - Estudiantes - Química Orgánica II Rev 2024 - 202553 páginas
- Guía de Aprendizaje: Instalaciones EléctricasAún no hay calificacionesGuía de Aprendizaje: Instalaciones Eléctricas7 páginas
- Proceso de Almacenamiento y Servicios de Materia PrimaAún no hay calificacionesProceso de Almacenamiento y Servicios de Materia Prima2 páginas
- Reglamento de Conducta en InformáticaAún no hay calificacionesReglamento de Conducta en Informática1 página
- Resultados de Bioseguridad en LaboratorioAún no hay calificacionesResultados de Bioseguridad en Laboratorio1 página